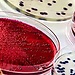
Rosa Puerta

Elena Landa
Escrito hace 6 años
Elena Landa
Escrito hace 6 años
Holaa!!! Soy Elena y estudio Farmacia en la Universidad del País Vasco. El año que viene estaré el curso entero en Coimbra. Me gustaría conocer a gente que también vaya.
Un saludo!
 Roberto Aguiar
Escrito hace 6 años
Roberto Aguiar
Escrito hace 6 años
Hola soy Roberto!
Ire a estudiar el año entero con otro amigo al instituto politecnico de coimbra.
¿Os parece hacer un chat o algo asi para comunicarnos mejor?
 Ana Valenzuela
Escrito hace 6 años
Ana Valenzuela
Escrito hace 6 años
Hola! Soy Ana, de la universidad de Granada, y voy el próximo año a la universidad de Coimbra para hacer 4º de Odontología. Me gustaría conocer gente que vaya allí de Erasmus!!
 Rosa Puerta
Escrito hace 6 años
Rosa Puerta
Escrito hace 6 años
Hola! Soy Rosa, estudio 3º de Farmacia en la universidad Miguel Hernandez (Alicante) e iré el próximo curso a la universidad de Coimbra. Me encantaría empezar a conocer gente!!!
 Laura Rodriguez
Escrito hace 6 años
Laura Rodriguez
Escrito hace 6 años
Buenas!! Estudio comunicación audiovisual + ADE en la URJC en Madrid y el año que viene voy a estar de erasmus en Coimbra en la universidad Miguel Torga. Me gustaría ponerme en contacto con los que también vais para ir consultando algunas cosillas! Un saludo!!!!
 Jairo Carrillo
Escrito hace 6 años
Jairo Carrillo
Escrito hace 6 años
Buenas!!! Soy Jairo, de Madrid. Estudio en la URJC y el año que viene estaré por Coimbra. Me gustaría ponerme en contacto con ustedes :)
Un saludo!!
 María Gil
Escrito hace 6 años
María Gil
Escrito hace 6 años
Hola! Soy María y estudio Enfermería en la Universidad de Murcia. El próximo curso estaré de erasmus en Coimbra haciendo 3º de Enfermería. Me gustaría empezar a conocer y ponerme en contacto con los que como yo también vayan a Coimbra el próximo curso.
Un besito!
 Marta Solana
Escrito hace 6 años
Marta Solana
Escrito hace 6 años
Holaaaaa!!! Soy Marta, de Cantabria. Estudio en la universidad de Cantarbia y el año que viene iré a Coimbra de erasmus el primer semestre con mi pareja. Me gustaría ponerme en contacto con la gente que vaya allí!!! Un beso!
 teresa carrilho
Escrito hace 6 años
teresa carrilho
Escrito hace 6 años
Holaa! Soy Teresa y el curso que viene estaré en Coímbra de erasmus. Estoy estudiando educacion primaria y me gustaría conocer gente antes de llegar allí. saludosss!!!
 Patricia Perez
Escrito hace 6 años
Patricia Perez
Escrito hace 6 años
Hola soy Patri y estudio farmacia en la Universidad de Valencia. Me voy de septiembre a julio a Coimbra de Erasmus.
Tengo muchas ganas de conocer a gente que vaya allí!
:)
 Leire Mardaras
Escrito hace 6 años
Leire Mardaras
Escrito hace 6 años
Holi, soy Leire!
Estudio Turismo en la Universidad de Deusto en Bilbao y el primer cuatrimestre del próximo curso estudiare en la Universidade de Coimbra!
 Javier Curiel
Escrito hace 6 años
Javier Curiel
Escrito hace 6 años
Hola, soy Javi!!
Estudio Comunicación Audiovisual en la UC3M y voy de erasmus el primer cuatri al Instituto Superior Miguel Torga. Me gustaría conocer gente que vaya a estar por allí de erasmus!
Encantado de conoceros y un saludo!
 María García-Pardo
Escrito hace 6 años
María García-Pardo
Escrito hace 6 años
Hola!!!! Soy María y estoy estudiando en Madrid Relaciones Internacionales, probablemente el curso que viene vaya a Coimbra y me gustaría conocer a gente que tambien vayan a estudiar alli.
 Rocío Erena
Escrito hace 6 años
Rocío Erena
Escrito hace 6 años
Hola!! Soy Rocío y estudio enfermería en la universidad de Jaén. El próximo año estaré el primer cuatrimestre en Coimbra :)
 Carmen López
Escrito hace 6 años
Carmen López
Escrito hace 6 años
Hola! Soy Carmen de Murcia, estudio Periodismo, y el curso que viene voy a estudiar en Coimbra, me gustaría conocer a gente que vaya!
 Marina Chacón
Escrito hace 6 años
Marina Chacón
Escrito hace 6 años
Hola me llamo Marina! Estudio ADE en la universidad Pablo de Olavide en Sevilla y me han dado el Erasmus para Coimbra el año que viene y me gustaría ponerme en contacto con la gente
 Eloy Rodríguez
Escrito hace 6 años
Eloy Rodríguez
Escrito hace 6 años
Hola!! Soy Eloy, estudio Biología en la Universidad de Granada y el próximo curso estudiaré en Coimbra. Me gustaría contactar con más gente que también vaya antes de llegar!!
 Maria Flores
Escrito hace 6 años
Maria Flores
Escrito hace 6 años
Hola, me llamo María estudio psicología en la universidad de Huelva y voy a cursar el primer semestre del próximo curso en Coimbra
 Sergio De
Escrito hace 6 años
Sergio De
Escrito hace 6 años
Hola¡¡¡ me llamo Sergio, tengo 20 años y estudio Ciencias del Deporte en la universidad de Toledo, el año que viene voy a ir a estudiar a la Universidad de Coimbra el tercer año de carrera y me gustaria conocer gente que fuese a mi universidad ;) , y como dato personal decir que soy una persona muy deportista, me gusta salir de fiesta y siempre me gusta hacer planes.
 Gloria González
Escrito hace 6 años
Gloria González
Escrito hace 6 años
Hola, me llamo Gloria!! Estudio Ciencias del deporte en la UEX en Cáceres. Voy a pasar el próximo curso en Coímbra, voy sola y me gustaría conocer a gente.